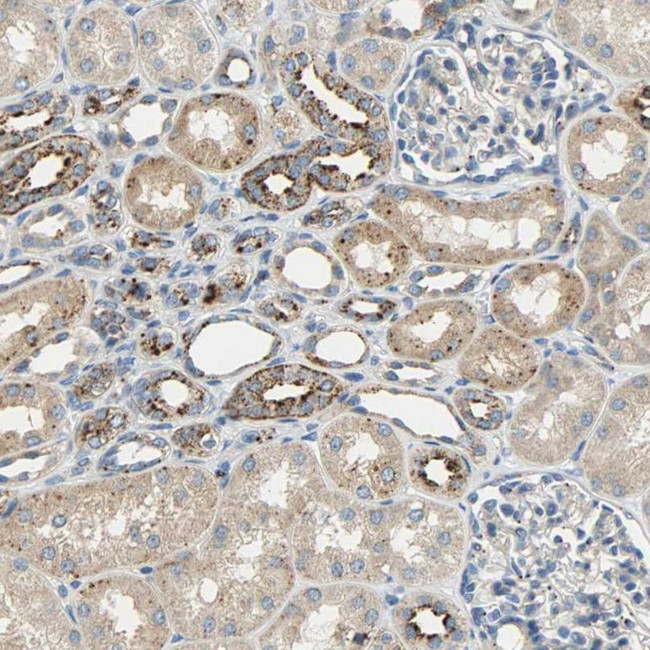
ASAH1 Antibody in Immunohistochemistry (IHC)

Search
Invitrogen
ASAH1 Polyclonal Antibody
{{$productOrderCtrl.translations['antibody.pdp.commerceCard.promotion.promotions']}}
{{$productOrderCtrl.translations['antibody.pdp.commerceCard.promotion.viewpromo']}}
{{$productOrderCtrl.translations['antibody.pdp.commerceCard.promotion.promocode']}}: {{promo.promoCode}} {{promo.promoTitle}} {{promo.promoDescription}}. {{$productOrderCtrl.translations['antibody.pdp.commerceCard.promotion.learnmore']}}
产品信息
PA5-52150
种属反应
已发表种属
宿主/亚型
分类
类型
抗原
偶联物
形式
浓度
规格
纯化类型
保存液
内含物
保存条件
运输条件
RRID
产品详细信息
Immunogen sequence: ENSTSYEEAK NLLTKTKILA PAYFILGGNQ SGEGCVITRD RKESLDVYEL DAKQGRWYVV QTNYDRWKHP FFLDDRRTPA KMCLNRTSQE NISFETMYDV LSTKPVLNKL TVYTTLIDVT KGQF
Highest antigen sequence identity to the following orthologs: Mouse - 82%, Rat - 86%.
靶标信息
ASAH1 encodes a member of the acid ceramidase family of proteins. Alternative splicing results in multiple transcript variants, at least one of which encodes a preproprotein that is proteolytically processed. The processing of this preproprotein generates alpha and beta subunits that heterodimerize to form the mature lysosomal enzyme, which catalyzes the degradation of ceramide into sphingosine and free fatty acid. This enzyme is overexpressed in multiple human cancers and may play a role in cancer progression. Mutations in this gene have been linked to the lysosomal storage disorder, Farber lipogranulomatosis, and a neuromuscular disorder, spinal muscular atrophy with progressive myoclonic epilepsy. The related pathways include Innate Immune System and Sphingolipid metabolism. Diseases associated with ASAH1 include Farber Lipogranulomatosis and Spinal Muscular Atrophy With Progressive Myoclonic Epilepsy.
仅用于科研。不用于诊断过程。未经明确授权不得转售。
生物信息学
蛋白别名: AC; acid CDase; Acid ceramidase; Acylsphingosine deacylase; Glycosylceramide deacylase; hydrolase; N-acylethanolamine hydrolase ASAH1; N-acylsphingosine amidohydrolase; N-acylsphingosine amidohydrolase (acid ceramidase) 1; PHP32; Putative 32 kDa heart protein; unnamed protein product
基因别名: AC; ACDase; ASAH; ASAH1; HSD-33; HSD33; PHP; PHP32; SMAPME
UniProt ID: (Human) E9PDS0
Entrez Gene ID: (Human) 427